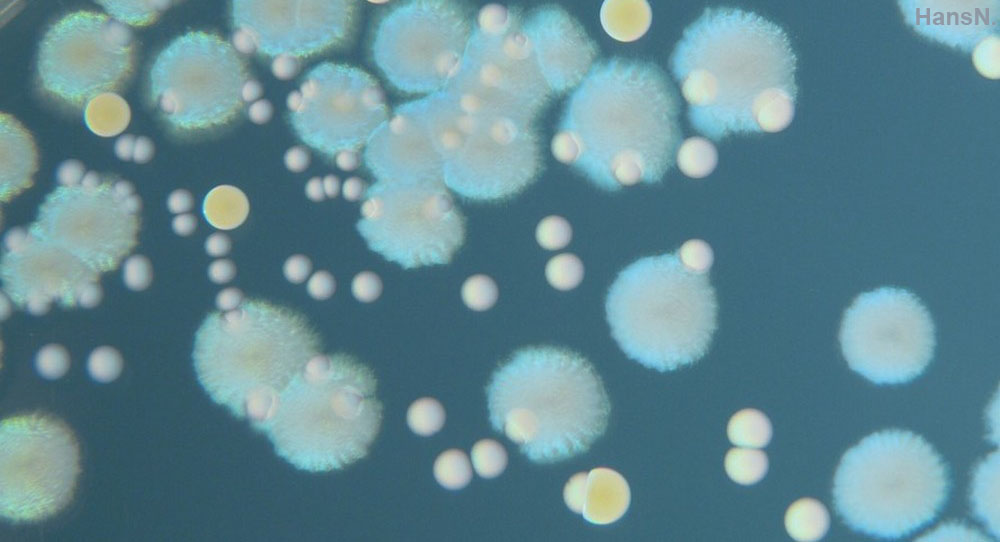

Bilder und Texte der Veranstaltungsfolien und -unterlagen sowie das gesprochene Wort innerhalb der Vorlesung und Lehr-Lern-Videos dienen allein dem Selbst- bzw. Gruppenstudium. Jede weiterführende Nutzung ist den Teilnehmenden der Moodle-Kurse untersagt, z.B. Verbreitung an andere Studierende, in sozialen Netzwerken, dem Internet. Darüber hinaus ist ein studentischer Mitschnitt von Webkonferenzen im Rahmen der Lehre nicht erlaubt.
Course slides and materials containing pictures and texts may only be used for self-study as well as group-study. This also applies to spoken contents in a lecture or an educational video. All further usage, such as the distribution on the internet, among other students or in social networks, is not allowed for any participants of the Moodle course. Moreover, the recording of web conferences in the context of teaching is prohibited for all students.